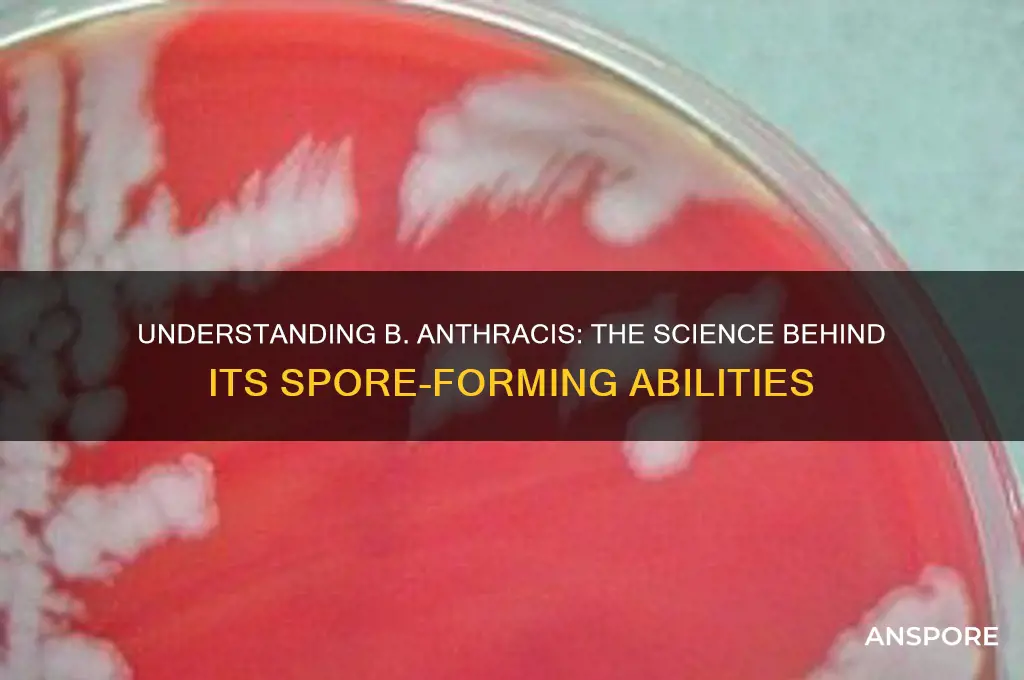
is b anthracis spore forming

*Bacillus anthracis*, the bacterium responsible for causing anthrax, is a spore-forming pathogen, meaning it has the ability to produce highly resilient endospores under adverse environmental conditions. These spores are metabolically dormant and can survive extreme temperatures, desiccation, and exposure to chemicals, allowing the bacterium to persist in soil for decades. When conditions become favorable, such as upon ingestion by a host, the spores germinate into vegetative cells, resuming growth and potentially causing disease. This spore-forming capability is a key factor in the bacterium's persistence in the environment and its potential use as a bioterrorism agent, making it a significant public health concern.
What You'll Learn
- Spore Formation Process: B. anthracis forms spores under stress, ensuring survival in harsh conditions
- Spore Structure: Spores have a protective coat, making them resistant to heat, radiation, and chemicals
- Spore Germination: Spores revert to vegetative cells when exposed to nutrients and favorable conditions
- Role in Pathogenicity: Spores are key to B. anthracis transmission, causing anthrax in hosts
- Detection Methods: Spores are identified via microscopy, PCR, and antibody-based assays for diagnosis

Spore Formation Process: B. anthracis forms spores under stress, ensuring survival in harsh conditions
Bacillus anthracis, the bacterium responsible for anthrax, is a master of survival, employing a remarkable strategy to endure adverse environments: spore formation. When faced with nutrient depletion, oxygen limitation, or other stressful conditions, this bacterium initiates a complex process to transform into a highly resilient spore. This cellular restructuring is a critical adaptation, allowing B. anthracis to persist in soil for decades, awaiting favorable conditions to revert to its vegetative, replicating form.
Understanding this process is crucial, as it underpins the bacterium's ability to cause disease and its potential use as a bioterrorism agent.
The spore formation process, or sporulation, in B. anthracis is a meticulously orchestrated sequence of events. It begins with the activation of specific genes in response to environmental cues, primarily the lack of essential nutrients. This genetic activation triggers the formation of a spore-specific cell wall and the synthesis of protective proteins, such as the spore coat and exosporium. The bacterial cell then undergoes asymmetric division, creating a smaller cell, the forespore, within the larger mother cell. This forespore is the precursor to the mature spore. The mother cell, in a sacrificial act, synthesizes and secretes the protective layers around the forespore, ensuring its survival. This process is a fascinating example of cellular altruism, where one cell dedicates its resources to safeguard the genetic material of another.
The resulting spore is an incredibly resilient structure, capable of withstanding extreme conditions. It can survive high temperatures, desiccation, and exposure to various chemicals, including some disinfectants. This durability is attributed to the spore's unique structure, which includes multiple protective layers and a dehydrated core containing the bacterial DNA and essential enzymes. The spore's ability to remain dormant for extended periods is a significant concern in the context of public health and bioterrorism, as it can be easily disseminated and remain viable until it encounters a suitable host.
In the context of anthrax infection, spore formation is a double-edged sword. On one hand, it ensures the bacterium's long-term survival in the environment, increasing the likelihood of transmission to susceptible hosts. On the other hand, the spore's resilience makes it challenging to eradicate from contaminated areas, posing a persistent threat. For instance, in the 2001 anthrax letter attacks in the United States, spores were used as a biological weapon, highlighting the ease of their dissemination and the severity of their impact. A single inhalation of 8,000 to 10,000 spores can lead to inhalation anthrax, a severe and often fatal form of the disease, emphasizing the importance of understanding and controlling spore formation.
Controlling and preventing spore formation is a critical aspect of managing B. anthracis as a potential threat. In laboratory settings, researchers study the sporulation process to identify potential targets for intervention. By understanding the genetic and environmental triggers, scientists aim to develop strategies to inhibit spore formation, thereby reducing the bacterium's ability to survive and cause disease. This knowledge is invaluable for public health officials and researchers working on bioterrorism defense, as it provides insights into developing effective decontamination procedures and potentially designing novel therapeutics to combat anthrax infections.
Play Spore on Chromebook: Easy Installation and Setup Guide
You may want to see also

Spore Structure: Spores have a protective coat, making them resistant to heat, radiation, and chemicals
Bacillus anthracis, the bacterium responsible for anthrax, is renowned for its ability to form highly resilient spores. These spores are not merely dormant cells but intricate survival structures engineered to withstand extreme conditions. Central to their durability is a multi-layered protective coat, a biological marvel that shields the spore’s genetic material from heat, radiation, and chemicals. This coat is composed of proteins, peptidoglycan, and an outer exosporium, each layer contributing to the spore’s near-indestructibility. For instance, the exosporium acts as a barrier against enzymatic degradation, while the inner layers provide structural integrity and chemical resistance.
To appreciate the spore’s resilience, consider its survival capabilities. B. anthracis spores can endure temperatures exceeding 100°C for hours, resist UV radiation exposure equivalent to weeks of direct sunlight, and remain viable in soils treated with disinfectants like bleach. This resistance is not passive; the spore’s coat actively prevents the penetration of harmful agents, ensuring the DNA inside remains intact. Such adaptability explains why anthrax spores can persist in the environment for decades, posing a long-term threat in contaminated areas.
Practical implications of this spore structure are significant, particularly in decontamination efforts. Standard sterilization methods, such as autoclaving at 121°C for 15 minutes, are often insufficient to eliminate B. anthracis spores. Instead, specialized protocols, including prolonged exposure to high heat (e.g., 160°C for 2 hours) or chemical treatments with agents like formaldehyde or hydrogen peroxide vapor, are required. For individuals handling potentially contaminated materials, wearing protective gear and adhering to strict decontamination procedures is non-negotiable.
Comparatively, the spore coat of B. anthracis shares similarities with other spore-forming bacteria like Clostridium botulinum, yet its resistance profile is uniquely tailored to its ecological niche. While C. botulinum spores thrive in anaerobic environments, B. anthracis spores are optimized for survival in soil, where they can remain dormant until ingested by a host. This specificity underscores the evolutionary precision of spore structure, a feature that makes B. anthracis both a scientific curiosity and a public health concern.
In conclusion, the protective coat of B. anthracis spores is not just a shield but a testament to the bacterium’s evolutionary ingenuity. Understanding its composition and function is critical for developing effective countermeasures, whether in laboratory settings, bioterrorism response, or environmental cleanup. By dissecting the spore’s structure, we gain insights into its vulnerabilities, paving the way for targeted interventions that can neutralize this persistent threat.
Manually Patching Spore: A Step-by-Step Guide for Gamers
You may want to see also

Spore Germination: Spores revert to vegetative cells when exposed to nutrients and favorable conditions
Bacillus anthracis, the bacterium responsible for anthrax, is a master of survival, thanks to its ability to form highly resilient spores. These spores can lie dormant in harsh environments for decades, waiting for the right conditions to spring back to life. When exposed to nutrients and favorable conditions, such as warmth, moisture, and specific biochemical signals, B. anthracis spores initiate a process called germination. This transformation is not merely a reactivation but a complete reversion to the vegetative, actively growing state, marking the beginning of a new infectious cycle.
The germination process is tightly regulated and begins with the spore sensing its environment. Key triggers include inositol hexakisphosphate (InsP6), a compound found in mammalian tissues, and certain amino acids like L-alanine. These molecules bind to specific receptors on the spore’s inner membrane, initiating a cascade of events. The spore’s cortex, a thick layer of peptidoglycan surrounding the core, is degraded by enzymes, allowing water to enter. This rehydrates the spore and reactivates its metabolic processes. Within minutes to hours, the spore sheds its protective coat and emerges as a vegetative cell, ready to multiply and produce toxins.
Understanding spore germination is critical for both medical and biodefense applications. For instance, anthrax spores can enter the body through inhalation, ingestion, or skin contact, but they remain dormant until they reach nutrient-rich environments like the lungs or bloodstream. Once germinated, the bacteria rapidly proliferate, releasing deadly toxins that cause tissue damage and systemic illness. This underscores the importance of early intervention—antibiotics like ciprofloxacin or doxycycline are most effective when administered before spores germinate, as they target actively growing cells, not dormant spores.
Practical strategies to prevent germination include controlling environmental factors. For example, soil contaminated with anthrax spores can be treated with formaldehyde or heated to 60°C for 30 minutes to inhibit germination. In laboratory settings, researchers use nutrient-rich media like brain-heart infusion (BHI) agar to study germination, often adding specific triggers like 10 mM L-alanine to observe the process under controlled conditions. For individuals at risk, such as veterinarians or lab workers, wearing protective gear and practicing strict hygiene can minimize exposure to spores before they germinate.
In summary, spore germination is a pivotal step in the life cycle of B. anthracis, bridging dormancy and virulence. By targeting this process—whether through environmental control, early antibiotic treatment, or laboratory research—we can mitigate the threat posed by anthrax spores. Recognizing the specific triggers and conditions required for germination not only advances scientific understanding but also informs practical strategies for prevention and treatment, ensuring a safer response to this formidable pathogen.
Ringworm Spores in Cats: Transmission, Prevention, and Control Tips
You may want to see also

Role in Pathogenicity: Spores are key to B. anthracis transmission, causing anthrax in hosts
Bacillus anthracis, the bacterium responsible for anthrax, owes its pathogenic success to its ability to form highly resilient spores. These spores are not merely a survival mechanism; they are the primary vehicle for transmission, enabling the bacterium to persist in the environment for decades and infect new hosts when conditions become favorable. Unlike the vegetative form of B. anthracis, which is susceptible to environmental stressors, spores are dormant, metabolically inactive structures encased in a protective protein coat. This durability allows them to withstand extreme temperatures, desiccation, and exposure to chemicals, making them nearly indestructible outside a host.
The process of spore formation, or sporulation, is triggered when B. anthracis encounters nutrient depletion or other adverse conditions. Once ingested or inhaled by a susceptible host—such as livestock, wildlife, or humans—the spores germinate, reverting to the vegetative form and beginning to multiply rapidly. This transformation is critical for the bacterium’s pathogenicity, as it allows B. anthracis to evade the host’s immune system initially and establish infection. For instance, inhalation of as few as 8,000 to 10,000 spores can lead to inhalational anthrax in humans, a severe and often fatal form of the disease if left untreated.
The role of spores in transmission is particularly insidious due to their ability to remain viable in soil, where they can contaminate grazing areas for animals or be inadvertently brought into human environments. This environmental persistence is why anthrax outbreaks often occur in agricultural settings or regions with a history of the disease. Once spores enter a host, they migrate to lymph nodes, where they germinate and produce toxins that cause tissue damage and systemic symptoms. The toxins, primarily edema toxin and lethal toxin, are the primary drivers of anthrax pathology, leading to symptoms such as fever, swelling, and respiratory distress.
Preventing spore-mediated transmission requires a multi-faceted approach. In agricultural contexts, vaccination of livestock is a cornerstone of control, reducing the risk of spore dissemination in the environment. For humans, particularly those in high-risk occupations like veterinarians or lab workers, personal protective equipment and strict handling protocols are essential. Decontamination of spore-contaminated areas is challenging, often requiring specialized methods like autoclaving or chemical treatment with chlorine solutions. Understanding the spore’s role in transmission underscores the importance of early detection and intervention, as prompt treatment with antibiotics like ciprofloxacin or doxycycline can prevent germination and halt disease progression.
In summary, the spore-forming capability of B. anthracis is not just a survival strategy but a key determinant of its pathogenicity and transmissibility. By forming spores, the bacterium ensures its longevity in the environment and its ability to cause anthrax in hosts. Recognizing this unique feature is crucial for developing effective prevention and control measures, from agricultural practices to public health responses. Whether in the field or the lab, addressing the threat of B. anthracis spores requires vigilance, knowledge, and targeted action.
Milky Spore Effectiveness in Maine: A Comprehensive Gardeners' Guide
You may want to see also

Detection Methods: Spores are identified via microscopy, PCR, and antibody-based assays for diagnosis
Bacillus anthracis, the bacterium responsible for anthrax, is indeed spore-forming, a characteristic that enhances its resilience and poses significant diagnostic challenges. Detecting these spores is critical for early diagnosis and containment, especially in potential bioterrorism scenarios or occupational exposures. Three primary methods—microscopy, polymerase chain reaction (PCR), and antibody-based assays—form the backbone of spore identification, each with distinct advantages and limitations.
Microscopy remains a foundational tool for spore detection, offering rapid visual confirmation of their presence. Spores appear as small, refractile bodies with a characteristic “box-car” appearance under bright-field or phase-contrast microscopy. For enhanced specificity, fluorescent antibody staining can be employed, targeting spore-specific antigens like exosporium proteins. While microscopy is cost-effective and accessible, it lacks sensitivity for low-concentration samples and cannot differentiate between viable and non-viable spores. For environmental samples, a concentration step, such as centrifugation or filtration, is often necessary to improve detection rates.
PCR-based methods provide unparalleled sensitivity and specificity, amplifying DNA sequences unique to B. anthracis spores. The *pagA* gene, encoding a protective antigen, is a common target, with detection limits as low as 10 spores per sample. Real-time PCR assays further enable quantification, aiding risk assessment in contaminated environments. However, PCR requires specialized equipment and trained personnel, making it less feasible in resource-limited settings. False positives can also occur due to DNA contamination, necessitating strict laboratory protocols. Despite these challenges, PCR remains the gold standard for molecular confirmation of spore presence.
Antibody-based assays, including enzyme-linked immunosorbent assay (ELISA) and lateral flow devices, offer a balance of speed and simplicity. These tests detect spore antigens or toxins like anthrax lethal factor (LF) and edema factor (EF). ELISA kits, for instance, can yield results within 2–4 hours with high specificity, making them suitable for clinical and field settings. Lateral flow devices, akin to rapid pregnancy tests, provide results in under 15 minutes but with lower sensitivity, typically detecting spore concentrations above 10^4 CFU/mL. These assays are particularly useful for initial screening, though confirmatory testing is often required.
In practice, a tiered approach combining these methods is ideal. Microscopy serves as an initial screen, PCR provides molecular confirmation, and antibody-based assays offer rapid triage in time-sensitive scenarios. For instance, in a suspected bioterrorism event, environmental samples could be screened via microscopy, followed by PCR for high-risk areas, and antibody-based tests for exposed individuals. Understanding the strengths and limitations of each method ensures accurate and timely detection, critical for managing the risks associated with B. anthracis spores.
Hydrogen Peroxide's Effectiveness Against C. Diff Spores: What Research Shows
You may want to see also
Frequently asked questions
Yes, Bacillus anthracis is a spore-forming bacterium, meaning it can produce highly resistant endospores under unfavorable environmental conditions.
B. anthracis spores are extremely durable and can survive in harsh environments for decades, including extreme temperatures, dryness, and exposure to many disinfectants, allowing the bacterium to persist in soil and other environments.
Yes, B. anthracis spores can cause infection in humans if inhaled, ingested, or introduced through breaks in the skin, leading to different forms of anthrax disease depending on the route of exposure.







